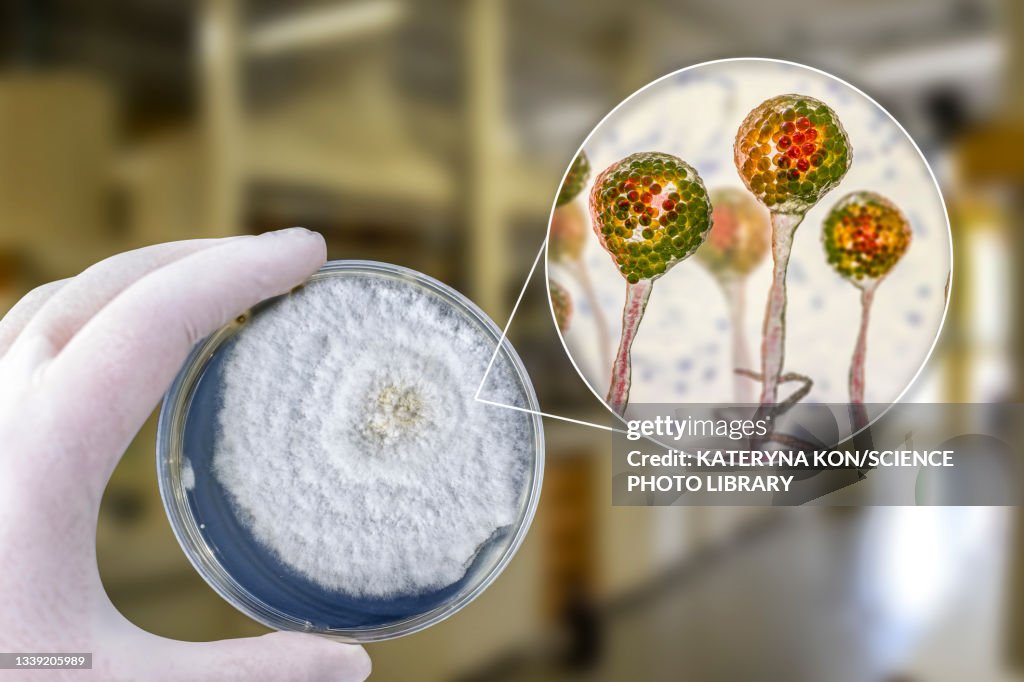
Pin mould (Mucor sp.), composite image

Pin mould (Mucor sp.), composite image - Stock-Grafiken
Composite image of mucor mould, also known as black fungus, and pin mould. Mucor sp. fungi are found in soil and decaying organic matter and are common indoor moulds. It can cause the rare but serious disease mucormycosis (zygomycosis) in patients that are immunocompromised or undergoing steroid therapy. The fungus can infect the lungs, sinuses, brain, gastrointestinal system, or the skin. In 2021 outbreaks of mucormycosis were seen in diabetic patients with Covid-19. Treatment is with antifungal drugs, although surgery is often needed to cut away the infected tissue.
Sichern Sie sich dieses Bild in einem von vielen Rahmen auf Photos.com.
EINE LIZENZ KAUFEN
Alle Lizenzen für lizenzfreie Inhalte beinhalten weltweite Nutzungsrechte, umfangreichen Schutz und eine einfache Preisgestaltung mit Mengenrabatten
335,00 €
EUR
Getty ImagesPin Mould Composite Image, Stock-Foto
Laden Sie authentische Premium-Grafiken zum Thema Pin mould (Mucor sp.), composite image von Getty Images herunter. Entdecken Sie ähnliche hochauflösende Grafiken in unserem umfangreichen Bildkatalog.Product #:1339205989
Laden Sie authentische Premium-Grafiken zum Thema Pin mould (Mucor sp.), composite image von Getty Images herunter. Entdecken Sie ähnliche hochauflösende Grafiken in unserem umfangreichen Bildkatalog.Product #:1339205989335€50€
Getty Images
In stockDETAILS
Bildnachweis:
Creative #:
1339205989
Lizenztyp:
Kollektion:
Science Photo Library
Max. Dateigröße:
6626 x 4417 px (56,10 x 37,40 cm) - 300 dpi - 9 MB
Hochgeladen am:
Releaseangaben:
Keine Freigaben erforderlich
- Pilz,
- Asexuellle Fortpflanzung,
- Biologie,
- Brotschimmelpilz,
- COVID-19,
- Composite-Technik,
- Dreidimensional,
- Farbbild,
- Forschung,
- Gesundheitswesen und Medizin,
- Hand,
- Handschuh,
- Horizontal,
- Hyphe,
- Illustration,
- Jochpilz,
- Judasohr - Speisepilz,
- Krankheitserreger,
- Kunstwerk,
- Labor,
- Makrofotografie,
- Medikament,
- Mikrobiologie,
- Mucormykose,
- Mykologie,
- Niemand,
- Petrischale,
- Schimmel - Pilz,
- Sporangie,
- Sporangiophor,
- Wissenschaftsberuf,